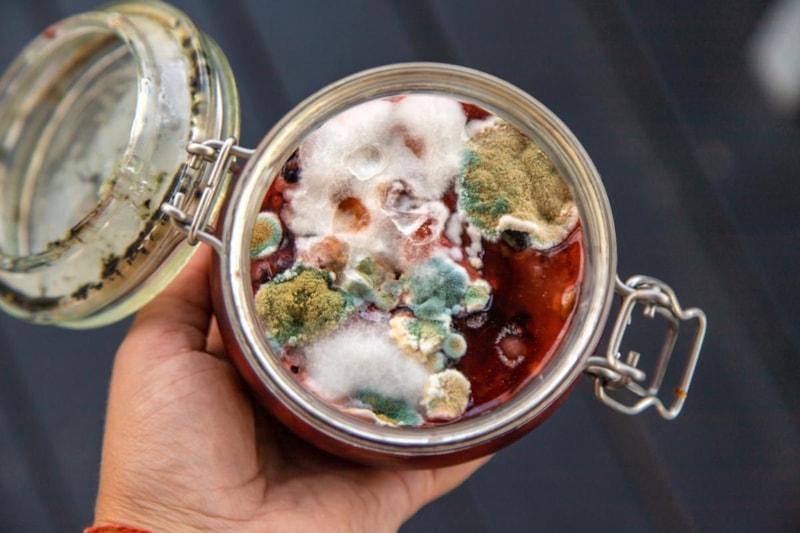

- Küflü yiyecekler ciddi sağlık riskleri taşıyan toksinler içerebilir.
- Ekmek, peynir ve kuruyemişler gibi gözenekli yapıya sahip gıdalar küflendiğinde tamamen atılmalıdır.
- Konservelerde küf veya şişme gözlemlenirse, besin güvenliği bozulmuş kabul edilir ve tüketilmemelidir.
Küflü yiyecekler göründüğünden daha büyük risk barındırıyor...
Yiyeceklerde çoğalan mantarların görünür hali, küf olarak biliniyor.
Bazı küf türleri, gıdayı hızla bozarken bazıları zehirli maddeler üretiyor.
Küf sporlarının solunması da alerjik reaksiyonlara ve solunum yolu sorunlarına neden olabiliyor.
Bu yüzden hangi yiyeceklerin küflenince mutlaka çöpe atılması gerektiğini bilmek, hem günlük sağlık hem de uzun vadeli korunma açısından büyük önem taşıyor.
KÜFLENİNCE ASLA TÜKETİLMEMESİ GEREKEN GIDALAR
1. YUMUŞAK MEYVELER
Bu meyveler yüksek su oranına sahip ve gözenekli yapıları nedeniyle küf hızla iç kısımlara kadar yayılıyor.
Görünmeyen kısımlarda da toksin bulunabileceği için kurtarmaya çalışmak güvenli olmuyor.
2. YUMUŞAK SEBZELER
Lifli ve sulu yapıları, küfün derinlere ilerlemesine yol açıyor. Yalnızca yüzeyi keserek tüketmek sağlık açısından riskli kabul ediliyor.

3. EKMEK VE DİĞER FIRIN ÜRÜNLERİ
Ekmek süngerimsi yapısı nedeniyle küf köklerinin tüm somuna yayılmasına elverişli oluyor.
Tek bir noktada küf görülse bile ürünün tamamı atılması gerekiyor.
4. YUMUŞAK PEYNİRLER
Nemli ve gözenekli oldukları için küf hızla peynirin içine işliyor.
Küf görüldüğünde tüm peynirin atılması gerekiyor.

5. SÜT BAZLI ÜRÜNLER
Bu ürünlerde küf yüzeyle sınırlı kalmıyor, kısa sürede tüm ürüne yayılıyor.
Bu nedenle üzerinde küçük bir küf noktası bile olsa tüketmek güvenli olmuyor.
6. KONSERVE YİYECEKLER
Konserve kutusunda küf veya şişme fark edildiğinde besin güvenliği bozulmuş sayılıyor.
Bu durum toksin ve zararlı bakteri varlığına işaret ediyor.
7. HAZIR YEMEKLER VE ARTAN EV YEMEKLERİ
Pişmiş yemekler uygun saklanmadığında küf ve bakteri için uygun ortam haline geliyor.
Üzerinde küf görülen yemeklerin tamamının atılması gerekiyor.
8. İŞLENMİŞ ET ÜRÜNLERİ
Bu ürünlerde oluşan küf genellikle zararlı kabul ediliyor ve atılması öneriliyor.
Sadece bazı kuru şarküteri ürünlerinde yüzeydeki küf silinebiliyor; ancak paketlenmiş dilimlenmiş ürünlerde risk daha yüksek oluyor.

9. KURUYEMİŞLER
Kuruyemişlerde oluşan küf güçlü bir toksin üretebiliyor.
Bu madde karaciğere zarar veriyor ve uzun vadede kanser riski oluşturabiliyor. Küflü kuruyemiş kesinlikle tüketilmemeli.
10. YER FISTIĞI VE MISIR
Bu gıdalar küf açısından en riskli ürünler arasında bulunuyor.
Uygun koşullarda saklanmadıklarında aflatoksin oluşma ihtimali artıyor ve bu da sağlık için tehlikeli sonuçlar doğurabiliyor.
